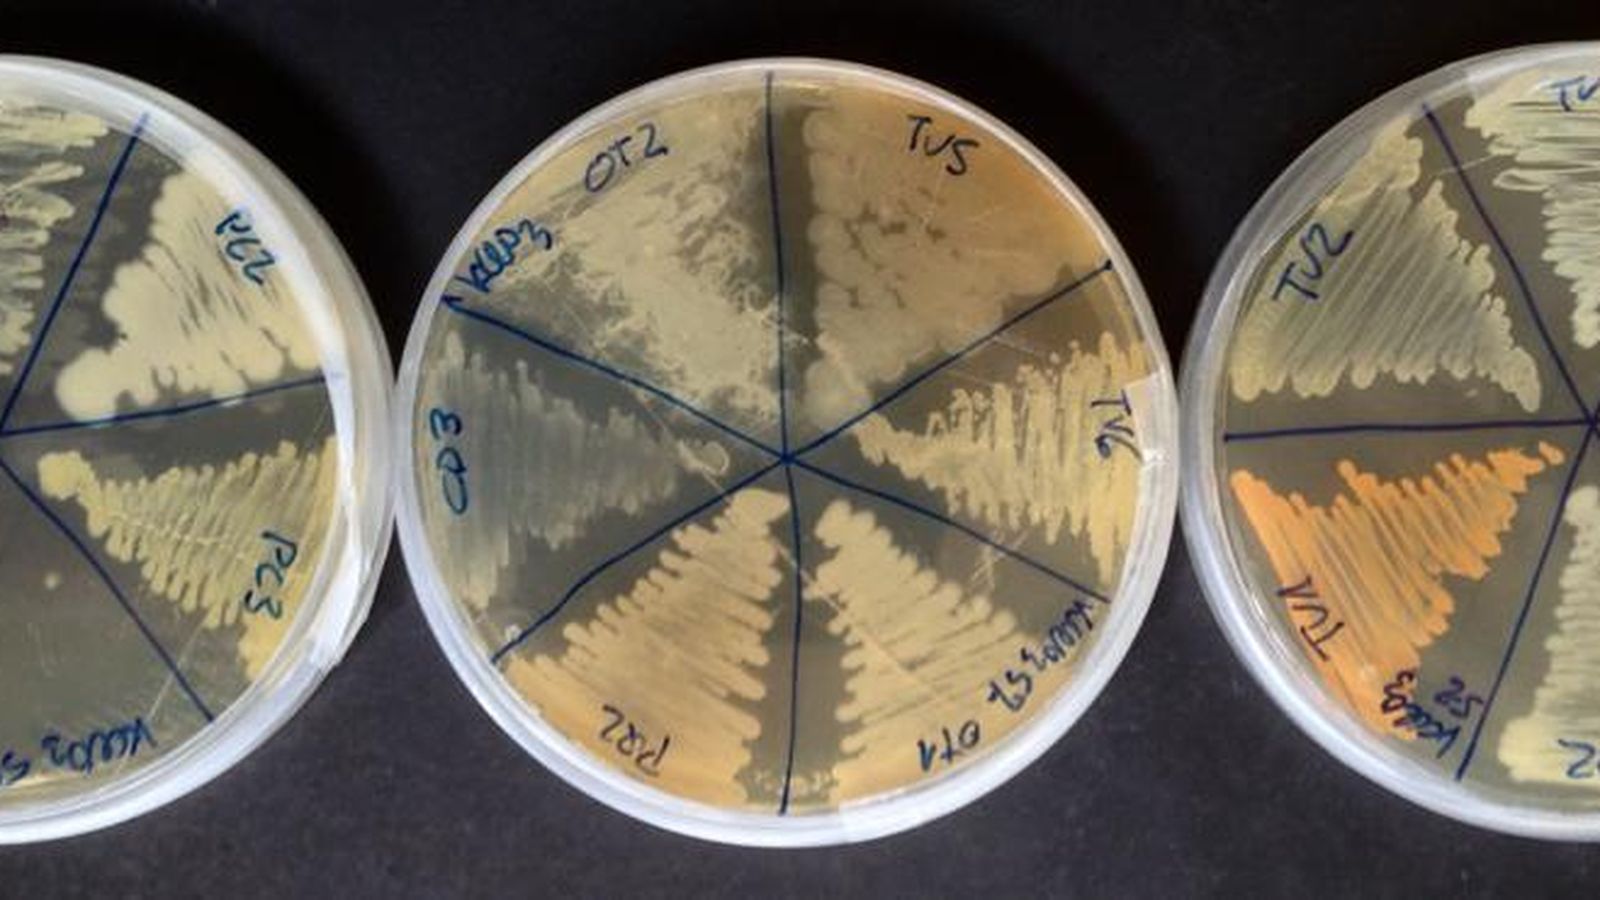
Cultivo en placas de Petri. Proyecto. `Mars revisited´ IES Zaidín Vergeles.

La investigación llega a institutos de Granada coordinados por la Estación Experimental del Zaidín
Educación
Ciencias Agrarias Online para Secundaria (CAOS) reúne ocho proyectos de investigación coordinados por la EEZ-CSIC, dirigidos a estudiantes de secundaria y bachillerato
Alumnado de la provincia, de Jaén y de Valencia presentan el 5 de mayo los primeros resultados del proyecto de educación científica “CAOS” II

El proyecto de educación científica 'Ciencias Agrarias Online para Secundaria (CAOS)' está llevando adelante ocho investigaciones dirigidas por personal científico de la Estación Experimental del Zaidín (EEZ-CSIC) y el profesorado participante. El objetivo es acercar la ciencia al alumnado de institutos de secundaria de Granada, Jaén y Valencia a través del uso de herramientas online.
Este jueves 5 de mayo, a las 17:00, se celebra en el salón de actos de la EEZ-CSIC el Congreso CAOS II. Los estudiantes de los institutos de Secundaria Francisco Ayala (Granada), Jándula (Andújar), Joanot Martorell (Valencia), Mariana Pineda (Granada), Padre Suárez (Granada) y Zaidín Vergeles (Granada) presentará los proyectos desarrollados este curso y responderán a las preguntas de los investigadores. El doctor Enrique Cerda, catedrático emérito del Departamento de Genética de la Universidad de Sevilla, cerrara el congreso con una charla dirigida al alumnado titulada 'El jardín de los senderos que se bifurcan'.
Este congreso forma además parte del programa Researchers at School, una iniciativa para apoyar al profesorado en el desarrollo de actividades de divulgación científica, en el marco del proyecto “La Noche Europea de l@s Investigador@s”.
Los proyectos
'Dear vegetable: How are you today?' está dirigido por José Manuel Palma (EEZ-CSIC) y Antonio Quesada (Instituto Zaidín Vergeles de Granada). Este proyecto se centra en valorar cómo distintos parámetros que afectan a la calidad de las frutas y verduras se van modificando a lo largo del tiempo cuando se conservan durante un tiempo determinado y diversas condiciones.

'El DNA 4 letras muy informativas (II) Definiendo y Estudiando los Retrones' está dirigido por Francisco Martínez (EEZ-CSIC) y Javier Julián Fernández (Instituto Joanot Martorell de Valencia). Alumnas de primero de bachillerato están aprendiendo cómo se trabaja con secuencias de ADN a través de programas informáticos. Les servirá de base para proponer un estudio comparativo.
'¿Protegen las mascarillas de infecciones bacterianas?' Está dirigido por Manuel Espinosa Urgel (EEZ-CSIC) y Lola Bernal (IES Francisco Ayala). Estudiantes de primero de bachillerato intentan averiguar cómo de eficaces son los distintos tipos de mascarillas frente a bacterias y esporas de mohos, a través del aprendizaje de técnicas microbiológicas.
'El polen en mi entorno (campiña vs serranía)' está dirigido por Juan de Dios Alché (EEZ-CSIC) y Sol de Torres (Instituto Jándula de Andújar, Jaén). La miel es un alimento de gran interés nutricional, además de poseer características saludables. El alumnado está analizando parámetros físico-químicos y de calidad, creando una polinoteca local y determinado el origen botánico de las mieles.
'Las plantas como fuente de energía eléctrica' está dirigido por Germán Tortosa (EEZ-CSIC) y José Emilio Padilla (Instituto Padre Suárez de Granada). Se pretende demostrar el efecto de la materia orgánica en los procesos redox del suelo rizosférico implicados en la generación de energía biofotovoltaica. Los estudiantes están construyendo un dispositivo para medir dicha energía eléctrica a partir de plantas. Además, evalúan si el uso del compost de biorresiduos favorece la producción energética.

'Las plantas del Mariana' está dirigido por María Eugenia Ramos (EEZ-CSIC) y Carlos Muñoz (Instituto Mariana Pineda de Granada). La filosofía del proyecto es involucrar a todo el alumnado, con la ayuda de los profesores de los diferentes departamentos didácticos. El objetivo es permitir que las personas que visiten o estudien en el centro puedan tener información sobre las plantas del instituto. Para ello se están realizando lecturas, fotografías, videos y audios musicales, dibujos, herbarios, talleres de cocina, entre otras actividades.
'Mars revisited' está dirigido por Manuel Espinosa (EEZ-CSIC) y Antonio Quesada (Instituto Zaidín Vergeles de Granada). Los estudiantes han aislado microorganismos resistentes a cloratos (compuestos tóxicos presentes en Marte), y aprenden cómo se han identificado a los microorganismos a lo largo de la historia y cómo se lleva a cabo actualmente su identificación mediante secuenciación genética.
'Pepper keeps dreaming of medicine: a project beyond the Project' está dirigido por José Manuel Palma (EEZ-CSIC) y Antonio Quesada (Instituto Zaidín Vergeles de Granada). Esta investigación parte de los resultados de un experimento llevado a cabo por un alumno del centro, sobre la trasmisión de la acrimonia (picor) de pimientos picantes a dulces cuando se siembran próximos. Los estudiantes participantes intentan dar una explicación a los resultados, así como plantear un nuevo diseño experimental que permita averiguar cuál es la causa del cambio se sabor.
También te puede interesar
Lo último








